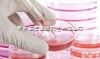
CBP6XXXX  <em>中科</em>院<em>上海</em>细胞库

6L2-AV 优势上海中科6L2-AV表头
- 型号:6L2-AV
- 产地:浙江 温州市
- 供应商:浙江中科机电有限公司
- 供应商报价: 15.00¥/台
- 标签:优势上海中科6L2-AV表头,优势上海中科6L2-AV表头价格,优势上海中科6L2-AV表头厂家
| 是否提供加工定制 | 是 | 类型 | 指针式电压测量仪表 |
| 品Pai | 其他 | 型号 | 6L2-AV |
| 测量范围 | 1-35(V) | 输入电压 | 100-220(V) |
| 输出电压 | 380(V) | 环境温度 | -20到40(℃) |
| 重量 | 1.5(g) | 外形尺寸 | 10(mm) |
| 电压测量误差 | ±15% |
产品分类:板表系列产品简述:6L2板表系列(80*80) ITIPANEL METER SERIES 电流(Current): 6L2-A 6L2-A 电压(Voltage): 6L2-V 6L2-V 频率(Frequency):6L2-HZ 功率(Power): 6L2-KW Mvar 功率因数(Power factor): 6L2-COSφ 同步表(Synchronoscope meter): 6L2-S产品描述: 本系列产品为磁电系和电磁系两种,适用于安装在各控制系统和配电系统的显示面板和大型开关板指示相关电参数,如:交直流电流、电压,功率因数,功率,同步值、频率、展开电压和过载电流等。产品性能符合GB7676-98标准。 二、主要技术参数 准确度为:1.5,2.5级;使用条件:-20~+50℃;相对湿度:≤85%;耐压影响:自频定值变化±15%,引起指示值误差不超过基本误差;机械性能:能承受加速成为30米/秒,冲击频率每分钟80-120次,二小时运输颠震;工作位置:垂直方向合使用 三、电流电压表测量范围
|